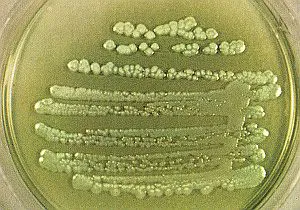
bacteria

bacteria
Lo más visto

Investigan posible negligencia de la madre tras el disparo que dejó a su hijo con muerte cerebral
Diario Móvil
El subsecretario de Inspección Damián Villavicencio explicó que el episodio es reciente y que se trabaja para establecer responsabilidades.

Tras una investigación coordinada por la Unidad Fiscal Federal, la Policía de San Juan concretó allanamientos en dos viviendas del departamento.

Cayó una banda de narcomenudeo: detuvieron a dos hombres con coca1na y marihu4na en Capital
Diario Móvil
Personal policial detuvo a dos sujetos a bordo de una motocicleta que transportaban estupefacientes y ofrecieron resistencia a la autoridad.

Facundo logró imponerse en las redes con una propuesta explosiva: “¿Cuál es el sentido de degradar a alguien porque no te gusta cómo se viste?“.

La víctima fatal del violento accidente ocurrido este sábado por la mañana en calle Vidart era de Santa Lucía.